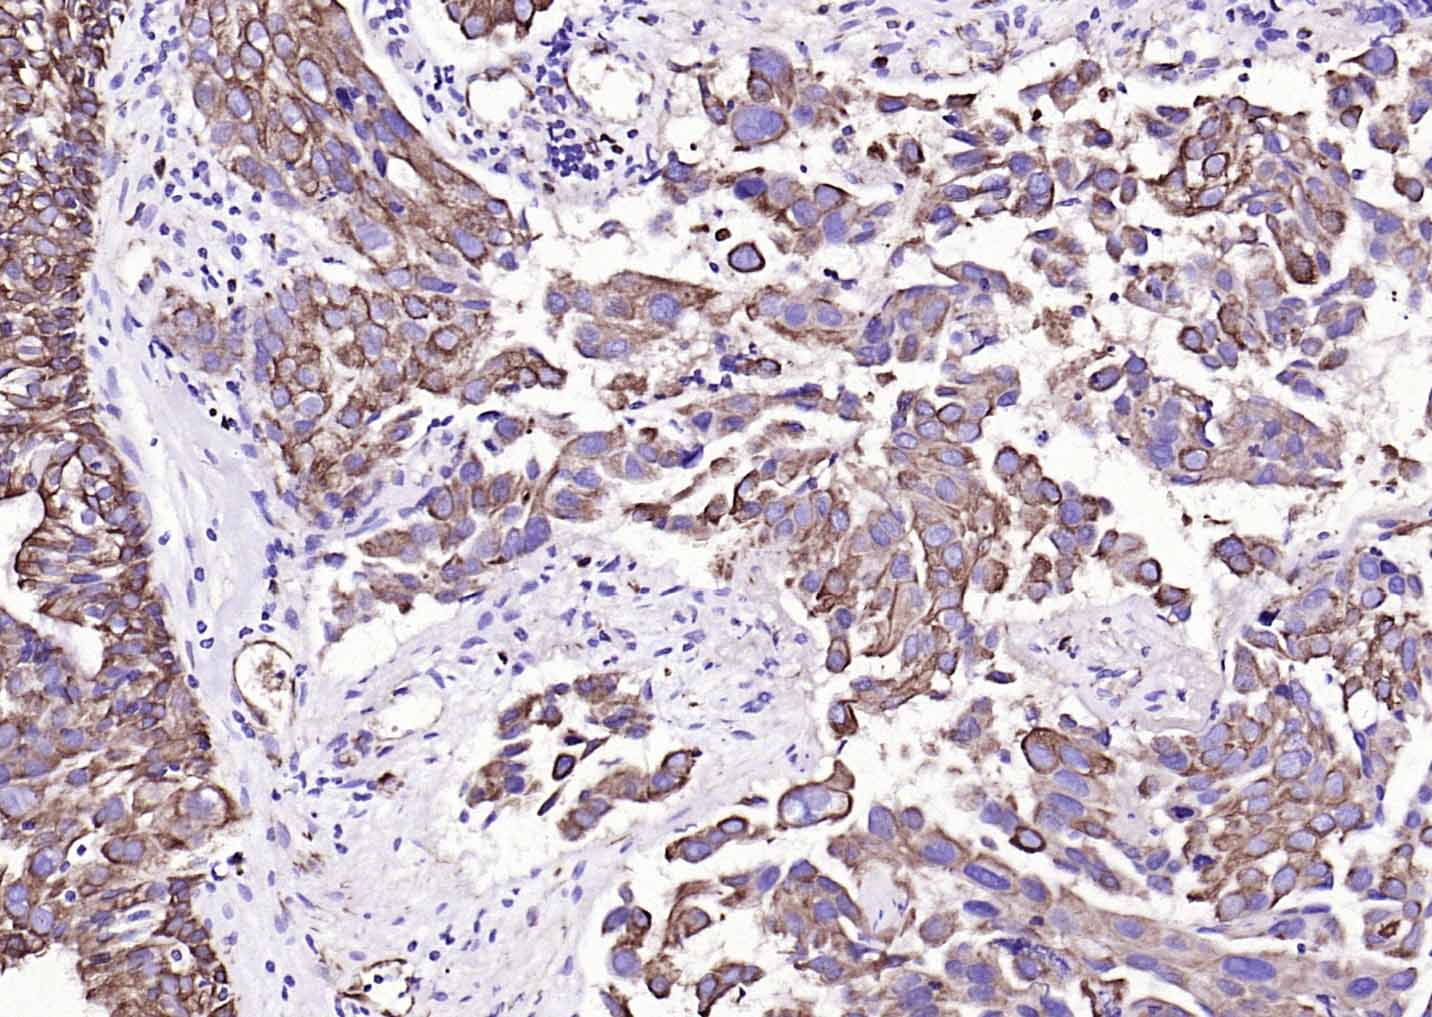
产品细节图片6
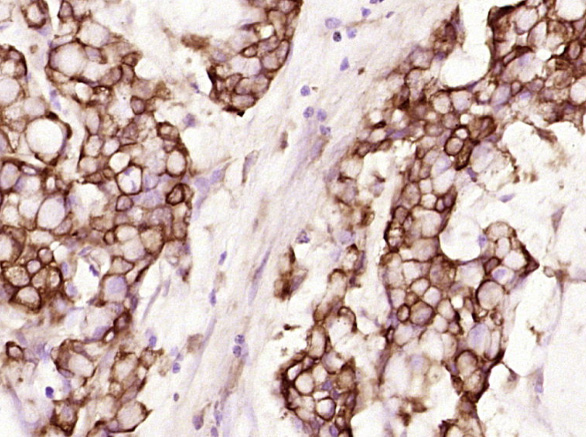
产品细节图片7

相关产品推荐更多 >

Cytokeratin 19 Rabbit pAb(bs-1028R)-50ul/100ul/200ul
¥1180
R-cadherin Rabbit pAb(bs-3675R)-50ul/100ul/200ul
¥1180
phospho-Eph receptor B1 (Tyr968) Rabbit pAb, AP conjugated(bs-10139R-AP)-100ul
¥2980
LRP5 Rabbit pAb, FITC conjugated(bs-4117R-FITC)-100ul
¥2980
CKMT Rabbit pAb, AP conjugated(bs-6522R-AP)-100ul
¥2980
万千商家帮你免费找货
0 人在求购买到急需产品
- 详细信息
- 文献和实验
- 技术资料
- 应用范围:
产品信息以Bioss网站为准
- 规格:
50ul/100ul/200ul/200ug
| 规格: | 50ul | 产品价格: | ¥1180.0 |
|---|---|---|---|
| 规格: | 100ul | 产品价格: | ¥1980.0 |
| 规格: | 200ul | 产品价格: | ¥2800.0 |
| 规格: | 200ug | 产品价格: | ¥5600.0 |
| 产品编号 | bsm-33057M |
| 英文名称 | Cytokeratin 19 Mouse mAb |
| 中文名称 | 细胞角蛋白19单克隆抗体 |
| 英文别名 | 40 kDa keratin intermediate filament; CK 19; ck19; CK19; CK-19; KRT19; Cytokeratin19; Cytokeratin-19; k19; k1cs; Keratin 19; Keratin-19; Keratin type I 40 kD; Keratin type i 40kD; Keratin type I cytoskeletal 19; krt19; mgc15366; K1C19_HUMAN; Keratin, type I cytoskeletal 19; Keratin, type I, 40 kd |
| 产品应用 | WB=1:500-2000, IHC-P=1:100-1500, IHC-F=1:100-1500, ICC/IF=1:100-500, IF=1:100-1500 Not yet tested in other applications. |
| 交叉反应 | Human, Mouse, Rat |
| 抗体来源 | Mouse |
| 免疫原 | KLH conjugated synthetic peptide derived from human Cytokeratin 19 |
| 亚型 | IgG |
| 性状 | Liquid |
| 纯化方法 | affinity purified by Protein G |
| 克隆类型 | Monoclonal |
| 理论分子量 | 44 kDa |
| 浓度 | 1mg/ml |
| 储存液 | 0.01M TBS (pH7.4) with 1% BSA, 0.02% Proclin300 and 50% Glycerol. |
| 研究领域 | Signal Transduction > Cytoskeleton / ECM > Cytoskeleton > Intermediate Filaments > Class I > Cytokeratins |
| 亚基 | Heterotetramer of two type I and two type II keratins. Interacts with PNN and the actin-binding domain of DMD. Interacts with HCV core protein. |
| 组织特异性 | Expressed in a defined zone of basal keratinocytes in the deep outer root sheath of hair follicles. Also observed in sweat gland and mammary gland ductal and secretory cells, bile ducts, gastrointestinal tract, bladder urothelium, oral epithelia, esophagus, ectocervical epithelium (at protein level). Expressed in epidermal basal cells, in nipple epidermis and a defined region of the hair follicle. Also seen in a subset of vascular wall cells in both the veins and artery of human umbilical cord, and in umbilical cord vascular smooth muscle. Observed in muscle fibers accumulating in the costameres of myoplasm at the sarcolemma in structures that contain dystrophin and spectrin. |
| 相似性 | Belongs to the intermediate filament family. |
| 功能 | Involved in the organization of myofibers. Together with KRT8, helps to link the contractile apparatus to dystrophin at the costameres of striated muscle. |
| 保存条件 | Shipped at 4℃. Store at -20℃ for one year. Avoid repeated freeze/thaw cycles. |
| 注意事项 | This product as supplied is intended for research use only, not for use in human, therapeutic or diagnostic applications. |
| 背景资料 | The protein encoded by this gene is a member of the keratin family. The keratins are intermediate filament proteins responsible for the structural integrity of epithelial cells and are subdivided into cytokeratins and hair keratins. The type I cytokeratins consist of acidic proteins which are arranged in pairs of heterotypic keratin chains. Unlike its related family members, this smallest known acidic cytokeratin is not paired with a basic cytokeratin in epithelial cells. It is specifically expressed in the periderm, the transiently superficial layer that envelopes the developing epidermis. The type I cytokeratins are clustered in a region of chromosome 17q12-q21. |
| 应用 | 推荐稀释比例 |
| {WB} | {1:500-2000} |
| {IHC-P} | {1:100-1500} |
| {IHC-F} | {1:100-1500} |
| {ICC/IF} | {1:100-500} |
| {IF} | {1:100-1500} |

风险提示:丁香通仅作为第三方平台,为商家信息发布提供平台空间。用户咨询产品时请注意保护个人信息及财产安全,合理判断,谨慎选购商品,商家和用户对交易行为负责。对于医疗器械类产品,请先查证核实企业经营资质和医疗器械产品注册证情况。
 文献和实验
文献和实验[IF={{ 4.2 }}] {Wei Zhu. et al. PRAG1 promotes cholangiocyte epithelial-mesenchymal transition and liver fibrosis in biliary atresia. BBA-MOL BASIS DIS. 2025 Nov;1871:167994} {IHC,IF} {Human}
[IF={{ 4 }}] {Zequan Ding. et al. CTHRC1 serves as an indicator in biliary atresia for evaluating the stage of liver fibrosis and predicting prognosis. DIGEST LIVER DIS. 2024 Jul;:} {IF,IHC} {Human}
[IF={{ 2.247 }}] {Qi Y et al. Denatured acellular dermal matrix seeded with bone marrow mesenchymal stem cells for wound healing in mice. Burns. 2019 May 6.} {IF} {Mouse}
Enrichment and Clonal Culture of Hepatic Stem/Progenitor Cells During Mouse Liver Development
and cytokeratin 19-positive bile ductal cells, indicating that these cells have the characters of liver stem/progenitor cells (proliferative capability and bipotency for hepatic and for biliary epithelial differentiation). These cells can maintain
Mouse anti-Human CD19 mAb,FITC 50T/100T 800/1200 L0055 Mouse anti-Human CD19 mAb,PE 50.100T 1000/1500 L0056 Mouse anti-Human CD19 mAb,PE-Cy5
The OP9-DL1 System: Generation of T-Lymphocytes from Embryonic or Hematopoietic Stem Cells In Vitro
. 2007. T-cell potential and development in vitro: The OP9-DL1 approach. Curr. Opin. Immunol. 19: 163168.[Medline] de Pooter, R.F., Schmitt, T.M., de la Pompa, J.L., Fujiwara, Y., Orkin, S.H., and Zúñiga-Pflücker, J.C. 2006. Notch signaling
 技术资料
技术资料暂无技术资料 索取技术资料






